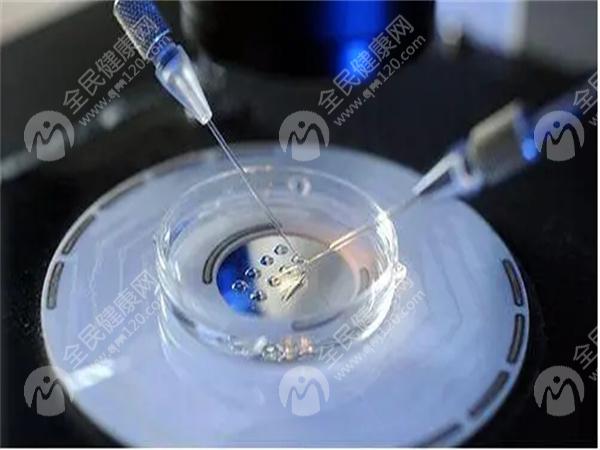

特别提示:接受试管婴儿技术的夫妇必须是合法夫妻,且仅限于治疗因特定不孕不育问题而无法通过其他方式怀孕的夫妇。
夫妻吵架致妻子胚停,医生盘点胚停原因胚胎停育(简称“胚停”)是指胚胎在母体内停止发育,通常发生在怀孕早期。这一现象不仅对孕妇和家庭带来极大的心理压力,也给医学界提出了许多挑战。本文将从医生的角度讨论导
试管婴儿
时间: 2025-03-30 13:15:03
6人阅读
夫妻吵架致妻子胚停,医生盘点胚停原因
胚胎停育(简称“胚停”)是指胚胎在母体内停止发育,通常发生在怀孕早期。这一现象不仅对孕妇和家庭带来极大的心理压力,也给医学界提出了许多挑战。本文将从医生的角度讨论导致胚胎停育的多种因素,帮助大家更好地了解和预防。
胚胎停育的一个重要原因与遗传异常有关。染色体数目或结构的异常会导致胚胎无法正常发育。常见的染色体异常包括三体综合征、单体综合征等。这些异常可能是父母一方或双方携带的隐性基因突变所引起的。此外,年龄也是一个重要因素,女性年龄越大,卵子质量下降,发生染色体异常的概率越高。
内分泌系统的紊乱也会引发胚胎停育。甲状腺功能异常、多囊卵巢综合征、黄体功能不全等问题都会影响激素水平,进而影响胚胎的着床和发育。例如,甲状腺功能减退可能导致胎儿生长迟缓;而黄体功能不足则会影响子宫内膜的准备状态,不利于胚胎着床。
免疫系统在维持妊娠中起着重要作用。如果母亲的免疫系统错误地识别胚胎为外来物并对其发动攻击,就可能造成胚胎停育。自身免疫性疾病如红斑狼疮、抗磷脂抗体综合症等,会增加这种风险。此外,母体的免疫反应过度活跃也可能导致流产。
某些病毒或细菌感染会对胚胎产生不利影响。风疹病毒、巨细胞病毒、弓形虫等病原体可通过胎盘屏障进入胎儿体内,干扰其正常发育。孕期感染不仅影响胚胎健康,还可能威胁到母亲的生命安全。
环境污染、化学物质暴露以及不良的生活习惯都可能成为胚胎停育的原因。长期接触有害物质如重金属、农药残留、放射线等,会损害生殖细胞的质量,增加胚停的风险。吸烟、饮酒、过量咖啡因摄入等不良生活方式同样不可忽视。
子宫是胚胎发育的重要场所,任何结构上的缺陷都会影响其功能。先天性子宫畸形(如双角子宫、纵隔子宫)、子宫肌瘤、子宫内膜息肉等病变均可能导致胚胎无法顺利着床或继续发育。宫腔粘连也是常见原因之一,它阻碍了胚胎与子宫壁之间的正常接触。
情绪剧烈波动和持续的精神压力被认为是诱发胚胎停育的心理因素之一。夫妻间频繁争吵、工作压力大、生活环境不稳定等因素,会使孕妇体内分泌过多应激激素,从而影响内分泌平衡,最终影响胚胎发育。特别是当情绪波动过于强烈时,可能会引起子宫收缩,影响胚胎稳定。
除了上述几类主要原因外,还有一些相对少见但同样重要的因素需要关注。例如,男性精子质量差、精液中存在大量畸形精子;或是夫妇双方染色体微缺失、微重复等情况,都可能导致胚胎发育异常。此外,不明原因的反复自然流产也值得关注,这类情况往往需要进一步深入检查才能找到确切原因。
综上所述,胚胎停育是一个复杂的过程,涉及多个方面的影响。对于有生育需求的家庭来说,提前做好相关检查,保持良好的生活习惯,避免不必要的精神压力,有助于提高胚胎着床成功率,减少胚停的发生几率。如果有过胚停经历的夫妇,在再次尝试怀孕前,建议进行全面评估,并根据医生指导采取相应措施,以确保母婴健康。
扩展阅读
相关推荐
更多
城市导航
推荐阅读
更多
相关知识
医生为什么告知说打了降调针之后不能生气?
2025-10-17 19:41:37 · 7 人浏览
新生儿败血症是什么病引起的?可以痊愈嘛?
2025-10-17 19:16:51 · 8 人浏览
2025年在招远市做高龄试管婴儿的成功率有多少?高龄试管婴儿有哪些注意事项?
2025-10-17 18:51:40 · 99 人浏览
2025年金华市可以做试管婴儿的医院有哪些?费用纳入医保了吗?
2025-10-17 18:01:38 · 5 人浏览
43岁做三代试管只移植一个胚胎能成功吗?
2025-10-17 17:36:48 · 8 人浏览
2025年都匀市哪个医院做试管婴儿比较专业?做试管婴儿的流程安排是怎么样的?
2025-10-17 16:47:05 · 98 人浏览
做试管婴儿胚胎移植前有必要查免疫全套吗?
2025-10-17 16:21:51 · 11 人浏览
做试管年纪比较大的人移植前打什么针较好?
2025-10-17 15:31:44 · 16 人浏览